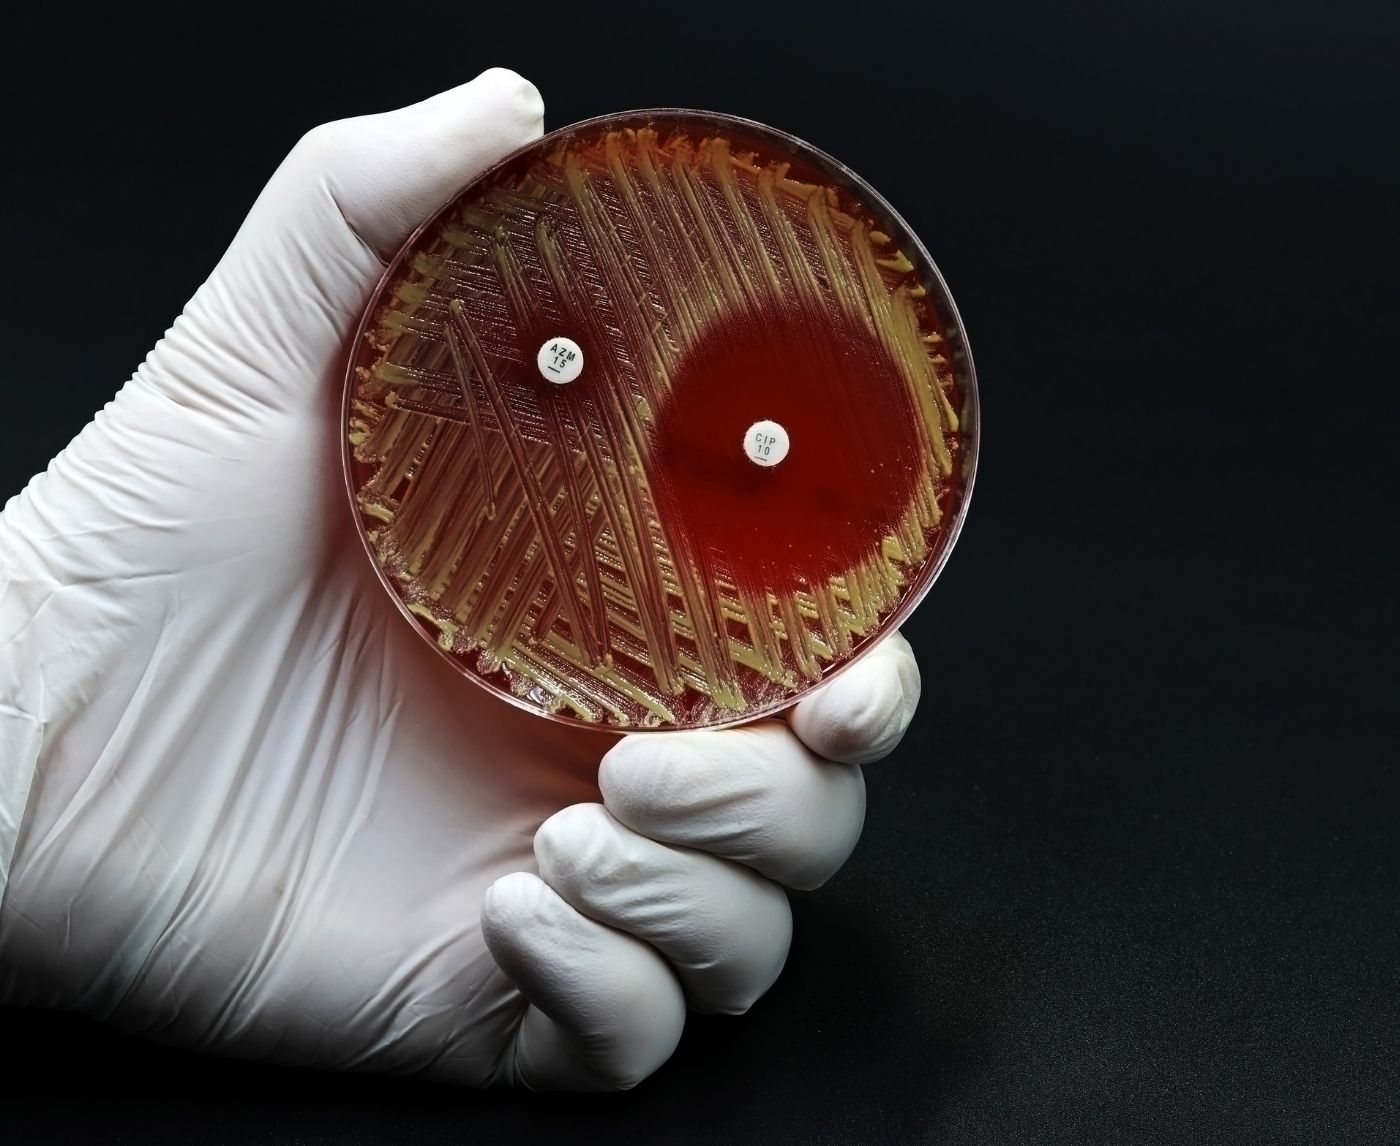
How Super Gonorrhoea Spreads (Even If You Use Protection)

Which STD Test Do I Need? A Simple Guide by Situation
Quick Answer: Super gonorrhoea spreads through oral, vaginal, and anal sex, and can infect the throat or rectum without symptoms. Condoms reduce risk but don’t eliminate it. Drug resistance is rising globally, making treatment harder and reinfection more common.
Why This Story Matters Right Now
If you’re reading this, you probably did what many do: used a condom, got tested, maybe even finished a round of antibiotics, and you're still wondering what’s going on. That’s not a failure. That’s reality in 2026. Gonorrhoea is mutating, and the version making headlines, antibiotic-resistant gonorrhoea, is spreading faster than most people realize.
In November 2025, the World Health Organization (WHO) issued a stark warning: cases of drug-resistant gonorrhoea are rising across every region of the world. Strains resistant to ceftriaxone, currently the last reliable injectable antibiotic, have now been reported in Brazil, India, South Africa, Sweden, and beyond. The spread is no longer regional; it's global.
This isn't just a public health issue, it’s personal. And if you're dating, having sex, or sharing intimacy with another person, it's your issue, too. So how does gonorrhoea keep spreading, even with condoms? Let’s break it down.

People are also reading: Do I Have to Tell My Partner I Had HPV in the Past?
How Gonorrhoea Can Slip Past Protection
Condoms are crucial. They reduce risk for a range of STDs, including gonorrhoea. But they’re not perfect, especially for a bacteria that can live in places you’re not protecting.
Gonorrhoea spreads through direct mucous membrane contact, meaning it can infect not just genitals, but also the throat, rectum, and urethra. Oral sex is a common route of transmission, and most people don’t use condoms or dental dams during it. Even if you used a condom during penetration, exposure from unprotected oral sex before or after can still transmit the bacteria.
And here’s the kicker: throat infections often have zero symptoms. That means someone can carry and spread gonorrhoea without knowing, even if they tested negative from a urine sample (which won’t detect throat infections).
“I Tested Negative Twice. Then It Hit Me.”
Marcos, 33, swore he was clean. He’d been tested twice in three months, always used condoms, and hadn’t had any genital symptoms. But then his boyfriend started showing signs of urethritis, pain, discharge, the works. When Marcos went back to the clinic, they swabbed his throat for the first time. The result? Gonorrhoea, likely oral-to-genital transmission.
“No one told me you could carry it in your throat without knowing. I felt betrayed by the system, not my partner.”
Throat gonorrhoea is one of the stealthiest forms of this infection. It doesn’t burn. It doesn’t discharge. It just sits there, waiting for the next encounter to jump hosts.
And because the throat is harder to treat, thanks to biofilm formation and lower drug penetration, it’s also a breeding ground for drug-resistant strains. That’s one reason super gonorrhoea is gaining ground.
What Makes It “Super”? Understanding Drug Resistance
“Super gonorrhoea” isn’t a medical term, it’s a public health warning. It describes gonorrhoea strains that resist multiple antibiotics, making them far harder to treat. These bacteria don’t just ignore one drug, they often shrug off three or more, including the ones we’ve relied on for decades.
Historically, gonorrhoea was treatable with penicillin or tetracycline. But over time, CDC data shows the infection has evolved resistance to nearly every drug thrown at it. Now, in many countries, ceftriaxone is the only option left, and resistance to it is growing. WHO’s surveillance shows ceftriaxone-resistant gonorrhoea jumped from 0.8% in 2022 to over 5% by late 2024.
Combine that with high rates of resistance to ciprofloxacin (up to 95% in some countries), and the situation becomes clear: the window to control this is shrinking. Treatment isn’t always working. And re-infection is getting harder to cure.
How Gonorrhoea Evolves: Sex, Speed, and Global Spread
Unlike many infections, gonorrhoea doesn’t need to make you sick to spread. That gives it an edge. Add in travel, hookup culture, stigma around testing, and a lack of symptoms in many carriers, and you’ve got the perfect storm for resistant strains to thrive.
This isn’t about blaming behavior. It’s about biology and public health. Gonorrhoea mutates quickly, especially when antibiotics are overused, misused, or interrupted mid-course. The more times it’s exposed to partial or poorly timed treatment, the better it gets at dodging future drugs.
Even in high-income countries, overprescribing and lack of test access fuel this evolution. And in low-resource settings, incomplete treatment due to cost or stockouts makes it worse. Super gonorrhoea doesn’t care about borders, it follows bodies, not passports.
Can You Still Get Gonorrhoea If You Use Condoms Every Time?
The honest answer? Yes, though your risk is lower.
Condoms reduce the risk of gonorrhoea, but they’re not a full barrier to all transmission routes. That’s because:
Table 1. Why condoms help, but don’t eliminate risk.
If you’ve ever skipped a condom for a “just oral” moment or assumed you were safe after one negative test, you’re not alone. But that’s exactly where super gonorrhoea lives, between assumptions, in those gray areas most sex ed never covered.
What About Testing? Why You Might Be Missing the Infection
One of the scariest things about super gonorrhoea is that it can hide, and not all tests catch it.
Most standard STD panels use a urine NAAT test (nucleic acid amplification test) to detect gonorrhoea and chlamydia. But if your infection is in the throat or rectum, and you weren’t swabbed there, it won’t show up. That’s how people spread it without realizing.
Testing is only as accurate as the sites you swab. If you’ve had oral, vaginal, or anal sex, you need a test that checks all relevant sites. At-home options are improving, but many still only offer urine-based tests unless specifically upgraded.
If you’re experiencing burning, discharge, rectal discomfort, sore throat, or just a gut feeling something’s off, don’t ignore it. Especially if symptoms persist after treatment or return quickly.

People are also reading: Why Chlamydia Is Often Missed in Young Women
Why Treatment Might Fail (Even If You Followed Instructions)
Getting treated and still testing positive isn’t always because you did something wrong. In today’s landscape, it’s often about which strain you caught, and how resistant it is.
Some strains of gonorrhoea now resist both oral and injectable antibiotics. According to WHO’s Enhanced Gonococcal Antimicrobial Surveillance Programme, resistance to ceftriaxone, the last reliable injectable treatment, is increasing in multiple regions.
Here’s how failed treatment often plays out:
Table 2. Why treatment isn’t always the end of the story.
Retesting is often essential, especially if your symptoms persist, your partner didn’t get treated, or your exposure risk continues. Even if you completed treatment, resistance means the infection may have survived.
What to Do If You Think You Have Super Gonorrhoea
If you’ve been treated and symptoms persist, or your partner was treated and you’re reinfected, it’s time to consider drug resistance. Here’s what to do next:
- Get retested, and make sure it’s site-specific. If oral or anal sex was involved, request throat and rectal swabs.
- Request a culture and sensitivity test if possible. This tells clinicians which antibiotics the strain is resistant to, helping them avoid another failed round.
- Get your partner(s) treated, even if they have no symptoms. Reinfection cycles are a major driver of resistant gonorrhoea.
- Abstain from sex until fully cleared by a healthcare provider. Using condoms while still infectious can still spread the bacteria if there’s oral contact or condom slippage.
- Ask your provider about follow-up testing. WHO and CDC recommend test-of-cure follow-ups when resistance is suspected.
This isn’t about shame. It’s about survival, for your health and your community’s. Drug-resistant gonorrhoea isn’t unbeatable, but it does require smarter, faster responses.
FAQs
1. Can you really get gonorrhoea even if you use a condom?
Yes, and it messes with people’s heads. You do everything “right,” and still get blindsided. Here’s why: condoms don’t cover everything, and gonorrhoea can spread through the throat, rectum, and even contact with infected fluids outside the condom zone. If oral sex happened, or things got touchy before the condom came on, it could’ve slipped through.
2. Wait… gonorrhoea in the throat? That’s a thing?
Absolutely. And the wild part? Throat gonorrhoea often has zero symptoms. No soreness, no visible signs, nothing. But it can still spread, especially during oral sex, and it’s a hot zone for super strains that resist antibiotics. That’s why throat swabs matter, even if you feel fine.
3. What makes it “super” gonorrhoea?
“Super” is just the scary nickname. What we’re really talking about is gonorrhoea that’s shrugged off multiple antibiotics, especially the big guns like ceftriaxone. It’s not invincible, but it’s smart, stubborn, and getting harder to treat.
4. How do I know if my gonorrhoea is drug-resistant?
If you’ve taken antibiotics and your symptoms are still hanging around, or they come back a few weeks later, that’s a red flag. Ask your provider about a culture and sensitivity test. That’s the only way to know which meds your strain still responds to.
5. I tested negative... but something feels off. Could I still have it?
Yes. Especially if your test didn’t include a throat or rectal swab. Standard urine tests can miss infections in other parts of your body. If your symptoms don’t match your results, trust your gut and ask for site-specific testing. You know your body better than any lab readout.
6. Can gonorrhoea go away without treatment?
Not a good idea to wait and see. Untreated gonorrhoea can lead to pelvic inflammatory disease, infertility, joint pain, and an increased risk of HIV. Drug-resistant strains won’t magically back down, they’ll just dig in deeper.
7. What if my partner tested negative, but I tested positive (again)?
Happens more often than people admit. Maybe they didn’t get a throat swab. Maybe they got treated but didn’t wait long enough before hooking up again. Or maybe they were never infected, and your case is lingering. Either way, it’s not about blame, it’s about full-body testing and full-circle care.
8. Are at-home STD tests accurate for this?
They can be, especially for genital infections. But most home kits still don’t swab the throat or rectum unless you specifically order multi-site testing. So if you’re worried about those areas, make sure the test matches your exposure.
9. Can I pass it to someone if I don’t have symptoms?
Unfortunately, yes. That’s one of gonorrhoea’s superpowers: stealth mode. You could feel completely fine and still pass it on. That’s why routine testing matters, not just when something burns.
10. How often should I be testing?
Depends on your life. If you have new partners often, hook up while traveling, or had a recent scare, every 3 to 6 months is smart. Otherwise, at least once a year. And don’t wait for symptoms. Most people who test positive didn’t feel anything at all.
You Deserve Answers, Not Assumptions
If something feels off, or if your last treatment didn’t seem to work, don’t settle for worry or guesswork. Drug-resistant gonorrhoea is rising, but knowledge, testing, and honest conversations are your strongest protection.
Get tested. Get site-specific results. And don’t let shame delay your next step. Our discreet at-home combo test kit makes it simple to check for gonorrhoea, chlamydia, and more from wherever you are.
Sources
1. WHO: More Countries Report Drug-Resistant Gonorrhoea
2. ASHA: Antibiotic-Resistant Gonorrhoea is Rising Globally
3. CIDRAP: WHO Warns of Drug-Resistant Gonorrhoea
4. Gonococcal Infections Among Adolescents and Adults – CDC
5. Gonorrhoea (Neisseria gonorrhoeae Infection) – WHO
How We Sourced This Article:We used up-to-date advice from top medical groups, peer-reviewed research, and reports from people who have lived through the issues to make this guide useful, kind, and correct. There were about fifteen sources that helped with the writing. Below, we've listed some of the most useful and easy-to-read ones.
About the Author
Dr. F. David, MD is a board-certified infectious disease doctor who specializes in preventing, diagnosing, and treating STIs. He combines clinical accuracy with a straightforward, sex-positive approach and wants to make it easier for people in both cities and rural areas to read his work.
Reviewed by: Dr. Lena Ortiz, MPH | Last medically reviewed: January 2026